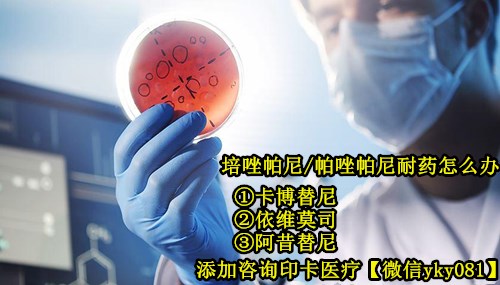

培唑帕尼对于肾癌患者和肉瘤患者来说是比较“耳能熟祥”的抗癌药。培唑帕尼治疗肾癌可帮助降低54%的肿瘤进展发生率,而接受培唑帕尼治疗的软骨肉瘤患者的无进展生存期有明显的改善,达到4.6个月,中位总生存期为12.6个月。维全特(培唑帕尼_帕唑帕尼)疗效好,但是和所以抗癌药一样也都有耐药周期,只是耐药周期因人而异。今天这篇文章,印卡医疗【微信yky081】围绕患者备受关注的“培唑帕尼耐药”及“破解方法”问题展开,具体内容如下。
培唑帕尼一般多久会产生耐药性?
“平均是半年到2年”。
培唑帕尼一般多久会产生耐药性具体还是因人而异的,因为导致培唑帕尼耐药的因素不是单一的,而往往是和患者疾病类型,病情,患者身体免疫力,心态,是否积极配合治疗,饮食生活方式是否健康等等都相关。所以要推迟培唑帕尼耐药时间,①是需要选择正确治疗方案积极配合治疗;②是不要漏服断药;③是保持乐观心态及健康生活饮食习惯。
维全特(培唑帕尼_帕唑帕尼)出现耐药后后续吃什么药了?
①肾癌患者在培唑帕尼耐药后可以选择:卡博替尼,依维莫司,阿西替尼。
②软骨肉瘤患者在帕唑帕尼耐药后,可以选择:帕唑帕尼 + PD1
索坦舒尼替尼,培唑帕尼(帕唑帕尼),卡博替尼,依维莫司,阿西替尼都是比较常见的口服抗血管生成肾癌靶向药,索坦(舒尼替尼)和维全特(培唑帕尼_帕唑帕尼),包括卡博替尼是一线用药,而依维莫司,阿西替尼是二线用药选择。也就是说肾癌患者绝大多数都是从索坦或者从培唑帕尼开始服用的。而对于肾癌骨转,卡博替尼是首选,因为卡博替尼不仅是肾癌用药而且也是目前治疗肿瘤骨转最好用药之一。在索坦舒尼替尼或者培唑帕尼耐药后再选择用药阿西替尼或者依维莫司。